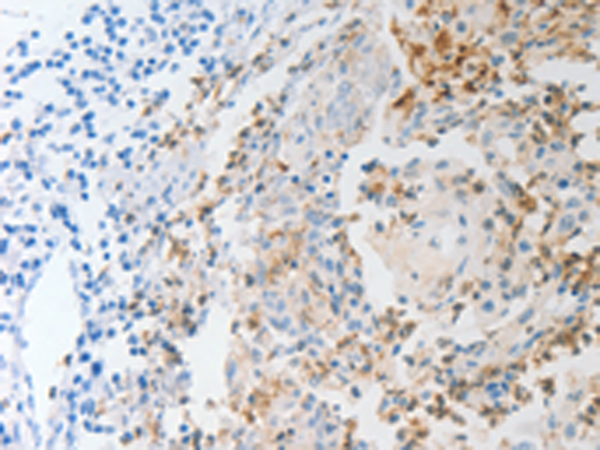

中文名稱: 兔抗NFKB2多克隆抗體
英文名稱: Anti-NFKB2 rabbit polyclonal antibody
別 名: p52, p105, H2TF1, LYT10, LYT-10, NF-kB2
相關類別: 一抗
儲 存: 冷凍(-20℃)
宿 主: Rabbit
抗 原: NFKB2
反應種屬: Human, Mouse
標 記 物: Unconjugate
克隆類型: rabbit polyclonal
技術規格
|
Background: |
This gene encodes one of the subunits of the transcription factor complex nuclear factor-kappa-B (NFkB). The NFkB transcription factor complex is expressed in numerous cell types and functions as a central activator of genes involved in inflammation and immune function. The NFkB complex can consist of different subunits that form both homo- or heterodimers which bind specific kappa-B elements in target genes. This gene encodes the p100 subunit that is processed into the active p52 subunit. This protein can function as both a transcriptional activator and repressor, depending on its dimer partner. Alternate splicing results in both coding and non-coding variants. |
|
Applications: |
ELISA, WB |
|
Name of antibody: |
NFKB2 |
|
Immunogen: |
Synthetic peptide of human NFKB2 |
|
Full name: |
nuclear factor of kappa light polypeptide gene enhancer in B-cells 2 (p49/p100) |
|
Synonyms: |
p52, p105, H2TF1, LYT10, LYT-10, NF-kB2 |
|
SwissProt: |
Q00653 |
|
ELISA Recommended dilution: |
2000-10000 |
|
WB Predicted band size: |
97 kDa |
|
WB Positive control: |
HT-29 and SKOV3 cells |
|
WB Recommended dilution: |
1000-5000 |
購物車
幫助
021-54845833/15800441009
